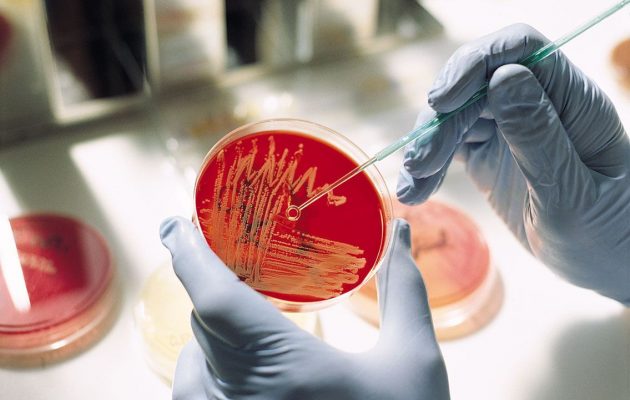
Пониженная средняя концентрация гемоглобина в эритроцитах

Средней концентрацией гемоглобинов в веществе эритроцитов является тот факт, когда делают анализ на кровь, ее обозначают при помощи МСНС. Иначе говоря, они определяют процент соотношения количественного показателя гемоглобинов. Подобная методика очень важная, так как выявляет точное значение.
Сдача анализа
Вычисление проводится при помощи определенных формул, в них учитывают гематокриты и уровни железосодержащих белков. Гемоглобин и эритроциты определяют среднюю концентрацию вещества в эритроците, при помощи проведения общего анализа. Его назначают пройти утром натощак, забирают кровь с пальца в лабораторных условиях. Все это необходимо для того, чтобы был точный показатель. За 10 часов до проведения процедуры необходимо не употреблять пищевые продукты, за два дня до процедуры отказаться от спиртных напитков, соков. Результаты определяют при проведении процедуры, используя гематологический анализатор.
Среднее содержание гемоглобина в эритроците МСН: нормами показателя МСНС являются такие нормальные значения, которые выявили в ходе исследования средний показатель. Это пределы от 300-380 грамм на литр. Отличие происходит, смотря от того, какой возраст и пол у пациента. У взрослого мужчины норма показателя — это от 322 до 355 грамм на литр. У взрослой женщины показатель 320- 350. Для ребенка показатель нормы немного другой, у детей до 5 лет это 270- 370. С 6 до 16 лет 320- 360. Все зависит не только от возраста, но и от весовой категории. Также влияет то, как человек питается, от его вредных привычек. Благодаря этому используется, чтобы выявить ошибку, когда проводится лабораторное исследование. Эритроцитарные индексы МСНС используют, если:
- оценивают эффективность терапевтического процесса, когда анемия;
- дифференциальная диагностика анемии;
- диагностируют гипохромию.
Также является такой процесс, который зачастую встречается, как патология. Когда в системе заболевание, то уровни показателя всегда повышаются. Это обусловливается тем, что происходит недостаточное поступление железа с едой или если происходит затруднительное усвоение вещества в кишечнике. А также наблюдается, когда происходят кровопотери в системе организма. Повышенная концентрация гемоглобина в эритроците характерность пониженного уровня эритроцита, также это образование происходит, когда в системе сильное кровотечение.
Выявление заболевания и причины отклонения
Зачастую происходит такое заболевание, как анемия и оно влияет на отклонение от нормы. Анемию также называют, как малокровие. Среднее содержание hb в эритроците: когда диагностируют это заболевание, то зачастую, проведение методик в виде анализов нВ, в этом случае, уровень вещества эритроцита и гемоглобина недостаточная методика. Средняя концентрация hb в эритроцитах, как правило, используют исследование параметров крови, при помощи которых совокупность создается, как полная картина повышенное содержание гемоглобина в эритроците. При помощи этого показателя выявляется точное состояние организма.
Влияет также определение цветового показателя. Средняя концентрация гемоглобина в эритроците МСНС: содержат низкий, когда среднее содержание гемоглобина в эритроците. Происходит повышение MCHC, то концентрации гемоглобинов в эритроците увеличиваются, если произошла анемия (гиперхромная). Это, в случае овалоцитоза, фолиеводефицитной формы, В 12 дефицитной формы, сфероцитоза врожденной и приобретенной формы. А также повышение происходит у новорожденного малыша и это норма показателя. Когда выявляется в ходе исследования повышенный показатель значений концентрационного содержании железосодержащих белков, то данное явление это редкость. Когда произошло увеличение показателя выше 390 и происходит повышение, то это может спровоцировать то, что произойдет кристаллизационный процесс в веществах.
Среднее содержание гемоглобина в эритроците понижено: при сниженном выявлении иногда бывает ошибочный вариант. Происходит это из-за того, что перед обследованием употребляли пищу и алкоголь. Бывают такие случаи, когда на повышенном уровне МСНС не связан с тем, что произошло заболевание в системе организма, а означает то, что при проведении диагностики выявили не точный результат. При повторном проведении выявляется точная картина. Средняя концентрация гемоглобина в эритроците: во многих случаях основа повышения MCHM происходит из-за некоторых недочетов.
При неправильном определении гематокритов, а также, если нарушено условие, при котором забирают кровь и хранят. Из-за чего и происходит частичное распадение веществ эритроцита.
Когда в организме содержится вещество, повышающее уровень показателя. Если произошло понижение МСНС, то это означает, что происходит в системе такое состояние, как заболевание в виде гипохромии. Это говорит о том, что красная клетка в недостатке насыщенна веществами гемоглобина. Такие состояния происходят из-за патологических процессов, при которых происходит нарушение производительности железосодержащего белка.
МСНС — это самый постоянный гематологический коэффициент, благодаря этому его использование необходимо, чтобы в случае ошибки в проведенном анализе ее обнаружили. Когда образуется в системе организма заболевание, то в первую очередь, происходит нарушение в синтезирования веществ гемоглобинов, а уровень МСНС понизится только в конце, когда компенсаторная реакция в организме исчерпалась. Из-за того, что произошло понижение значения МСНС, как нормальное содержание эритроцита и гемоглобинов в кровяной системе. Все это означает, что обследование провели неверно.
Определение результатов
Средняя концентрация гемоглобина в эритроците повышена: при проявлении гипохромии, которая образуется, как правило, при различных формах анемических процессов при гиповитаминозе, если произошло отравление веществом свинца, а также, как следствие наследственных врожденных заболеваний. Это также происходит, когда произошло нарушение в системе организма при обмене веществом железа. Данное образование провоцируют такие факторы, как сидеробластическая и гипохромная железодефицитная анемия. Когда глоглобинопатия, при которой нарушается синтезирование вещества гемоглобина.
При талассемии – это является наследственной болезнью, которая произошла из-за мутации в гене. А они производят синтезирование железосодержащих белков. Если это произошло у ребенка, то содержащееся вещество всегда выявляют в ходе обследования. При его помощи отражается, какая насыщенность красного кровяного тельца гемоглобином. Если повышен гемоглобин у женщин, то происходит определенная симптоматика. Высокий гемоглобин у женщин возникает, когда наблюдается гормональный сбой в системе. Причиной, по которой произошло понижение в системах средних концентраций гемоглобинов в эритроците — это может быть образование лейкоцитоза, если произошла длительная необильная кровопотеря, то среднее содержание гемоглобина в эритроците повышено.
При резком росте объемности эритроцита, если нарушена выработка вещества гемоглобинов при гиповитаминозе. Если повышенный гемоглобин, то это означает сбой в системе организма. Но, когда показатель резко снижается, то отсюда следует, что самостоятельные показатели при выявлении причин, когда понижен гемоглобин МСНС, категорически запрещено использовать. Когда снижается синтез веществ гемоглобинов, то в системе организма это проявляется, как средняя концентрация в эритроците. Это осуществляется, как самый последний вариант. По тому, какие уровни средних концентраций в эритроцитах не может дать определение объема веществ в кровяной системе.
Наличие гемоглобина в эритроцитах выявляется в ходе исследования. Совокупности данных значений, как отдельные показатели помогают сделать полную оценку уровня гемоглобина, а также в случае развития анемии выявить образование заболевания. В любом случае, если произошло отклонение от нормы, то специалист назначит правильные методики по его устранению. При помощи данного исследования определяется точное состояние в системе, если соблюдать все те рекомендации, которые врач назначил перед проведением процедуры, то ответ будет правильным.
За что отвечает гемоглобин в крови?
MCH в анализе крови (гемоглобин) играет роль элемента, окрашивающего кровь в красный цвет. Благодаря специфической структуре гемоглобин способен связывать в несколько элементов (углекислый газ, углекислоту и кислород), находящихся в составе крове, для дальнейшего перемещения по кровеносной системе к органам.
Важно! У взрослого человека среднее значение гемоглобина является постоянной единицей, у детей индекс колеблется то в сторону снижения, то в сторону повышения. Однако при отсутствии подготовки к исследованию общий анализ крови у взрослого пациента может показать, что среднее содержание гемоглобина в эритроците понижено или повышено, и будет считаться ложным результатом.
Как определить показатель гемоглобина в эритроците?
Чтобы определить среднее содержание Hb в эритроците пациента, понадобиться специальное медицинское оборудование и кровь обследуемого, взятая из капилляров. Данный анализ крови проводится натощак в утренние часы, так как в остальных случаях результаты проведенного исследования могут быть неверными.
Если пациент находится на медикаментозном курсе лечения, то до ОАК отказаться от приема препаратов, так как они могут пагубно повлиять на показатель МСНС в анализе крови. С помощью гематологического анализатора врач определяет среднюю концентрацию гемоглобина и передает результаты специалисту, который ставит объективную оценку. Процедура занимает от 3 до 5 дней.
Причины понижения и повышения концентрации Hb в эритроцитах
Если по результатам общего анализа крови окажется, что у пациента средняя концентрация гемоглобина в эритроците понижена, то такое отклонение свидетельствует о наличии патологии в организме. Распространенными заболеваниями, при которых Hb в эритроците понижено, считаются:
- Гиповитаминоз.
- Анемия.
- Токсическое отравление свинцом.
- Нарушение процесса выработки гемоглобина.
- Талассемия (нарушение в генах, отвечающих за производство железосодержащего белка).
- Увеличение числа эритроцитов.
- Перенесенное длительное кровотечение.
- Лейкоцитоз.
Основные причины понижения средней концентрация Hb в эритроцитах кроются в патологиях, которые способствуют нарушению выработки железосодержащего белка. Однако существует железодефицитная анемия, при которой низкий уровень гемоглобина в эритроцитах отмечаться не будет.
Помимо ситуаций, когда средняя концентрация гемоглобина в эритроцитах понижена, могут отмечаться и случаи, когда индекс отклоняется в сторону увеличения. Зачастую,такое явление свидетельствует о:
- Нарушениях водно-электролитного обмена.
- Одним из типов гиперхромной анемии (сфероцитоз, овалоцитоз, фолиеводефицитин и т.д.).
Повышение индекса средней концентрации гемоглобина в эритроцитах встречается редко и в большинстве случаев свидетельствует о нарушении во время проведения общего анализа крови. Подобное отклонение может встречаться у новорожденных детей, но в таком случае расценивается как норма.
Важно! Причины понижения средней концентрации гемоглобина в эритроцитах у ребенка более обширны, так как связанны с патологиями, клиническими состояниями, природным развитием организма.
Норма концентрации Hb а эритроцитах у детей и взрослых
Гемоглобин, содержащийся в эритроцитах человека, имеет свою норму, на которую врачи ориентируются во время исследования крови пациента. Показатель зависит от возраста обследуемого и выглядит следующим образом:
- В возрасте от 1 месяца, до 4 лет норма концентрации гемоглобина составляет от 280 до 380 г/л.
- В возрасте от 5 до 14 лет норма будет колебаться в пределах 322 – 368 г/л.
- В возрасте старше 15 лет норма концентрации гемоглобина в эритроцитах будет составлять от 322 до 355 для женщин и от 323 до 365 г/л для мужчин.
До 15 лет отмечается один показатель гемоглобина для обоих полов, в зрелом возрасте индекс отличен для мужского и женского пола.
Индекс средней концентрации гемоглобина в эритроците
МСНС является показателем, обозначающим приблизительное содержание такого пигмента, как гемоглобин, в имеющейся у человека системе кроветворения.
Важно! Данные (Mchc) обусловлены именно количественным соотношением описываемого содержимого к объему той или иной клетки в системе кроветворения в независимости от имеющегося числа эритроцитов.
И если необходимо определить концентрацию клеточного гемоглобина в эритроцитах, для выявления того или иного недуга, путем обследования, медицинский работник прибегает к гематологическому оборудованию специального назначения. Подобный тестовый анализ сдается с утра на голодный желудок из пальчика в лабораторных условиях.
Для большей достоверности анализа целесообразнее отказаться от приема пищи и любого алкоголя как минимум за 10 часов до начала самого обследования.
На протяжении всего жизненного пути средний показатель МСНС в крови у человека меняется. У только что родившегося младенца, к примеру, описываемый показатель намного ниже, в сравнении со значением Mchc взрослых мужчины или женщины. С течением времени у человека достигшего подросткового возраста уровень содержания пигмента в кровяных тельцах достигает соответствующей нормы. И для того чтобы суметь правильно истолковать полученные результаты сданного анализа крови необходимо разбираться в норме показателей того или иного возрастного периода обязательно учитывая при этом пол человека.
Чем определена норма МСНС
Для людей в возрасте до 15 лет нормой данные содержания пигмента в крови являются:
- От рожденья до 2-х недель – 280-350 гр./л;
- От 14 дней до месяца – 280-360 г/л;
- От 1 до 2-х месяцев – 280-350 гр./л;
- От 2-х до 4-х месяцев – 290-370 г/л;
- От 4-х месяцев до года – 320-370 гр./л;
- От года до 3-х лет – 320-380 г/л;
- От 3-х до 13 лет – 320-370 гр./л;
- От 13 лет и до 15-летнего возраста: для мужчин положено содержание 320-370 грамм/литр, а для представительниц слабого пола – 320-360 гр./л.
Показателями нормы для взрослого поколения людей перешагнувших подростковый возраст являются:
- В возрасте от 15 и до 45 лет – 320-360 грамм/литр;
- От 45 до 60 лет: для мужчин – 320-360 грамм/литр, а для представительниц прекрасного пола – 310-360 гр./л;
- Для пациентов, перешагнувших 65-летний возрастной рубеж: норма для мужчин 310-360 грамм/литр, для женщин 320-360 грамм/литр.
Причины пониженной средней концентрация гемоглобина в эритроците
При отклонении имеющихся показателей от нормы (со значимым ее понижением) можно говорить, например, о такой болезни, как гипохромия, которая развивается в результате недостаточного вбирания клетками, кровяными тельцами такого содержимого, как гемоглобин.
Подобное состояние зачастую бывает обусловлено рядом патологий, существующих в человеческом организме из-за которых и нарушается производство кровяного элемента, названного гемоглобином.
Пониженному уровню МСНС способствуют причины типа:
- Гипохромных анемий сидеробластического и железодефицитного характера;
- Постгеморрагических анемий с имеющимся хроническим течением болезни;
- Гемаглобинопатии – нарушения синтеза описываемых частиц;
- Нарушений, связанных с недостаточностью обменных водно-электролитных процессов;
- Патологических состояний генетической направленности.
При любых нарушениях, связанных с гемоглобиновым синтезом показатели сниженного МСНС в системе кроветворения определяются в самом конце. И если при обследовании результаты индекса (Mchc) понижены, а сами кровяные тельца и железосодержащий элемент при этом находится в норме, допустимо вести речь об ошибочном проведении текущего исследования.
Возможные последствия
Последствия тех или иных анемий могут пагубно влиять на деятельность человеческого организма. Первоначально может нарушиться система пищеварительного процесса, гормональный фон организма, что отразится на внешности болеющего человека в виде бледности кожного покрова, выпадения волос, ломкости ногтевых пластин.
Кроме того, могут развиться патологические состояния типа:
- Изменений структуры мозга;
- Сердечно-сосудистых заболеваний;
- Пониженного артериального давления;
- Вкусовых, осязательных и обонятельных нарушений;
- Нарушений вестибулярного аппарата;
- Болезненности и судорог в той или иной области тела.
Необходимая терапия при пониженном индексе МНСН
При обнаружении пониженного уровня концентрации железосодержащего белка в подобных элементах медицинскими работниками назначается терапевтическое лечение с использованием медикаментозных препаратов способных повысить уровень МНСН.
Определившись с причинами снижения уровня МНСН, медиками разрабатывается индивидуальный план терапевтического лечения. Основой такого лечения являются:
- Комплекс витамин с входящим в его состав элементом группы «В»;
- Минеральные компоненты и добавки;
- Препараты, насыщенные таким компонентом, как фолиевая кислота и железо.
При описываемом дефиците пигмента в клетках, пациентам не достигших 3х летнего возраста рекомендуется прием препаратов в виде Ферума, Лека, Актифферина, Детям же старшего возраста показан прием средств, в виде Тотема, Ферроплекса, Тардиферона. Назначение именно этих препаратов обусловлено содержанием в их составе природных элементов, которые в процессе лечения некоим образом не смогут навредить детскому еще неокрепшему организму.
Лечебный же процесс, взрослого поколения основывается на этих же лекарственных препаратах, но в значительно большей дозировке. Время назначенного курса лечения варьируется в пределах от 1-го до 3-х месяцев, а частотность приема и индивидуальная дозировка рассчитывается лечащим доктором с учетом всех особенностей организма того или иного пациента, а также на основании причин, приведших к такому состоянию.
Дополняется вышеописанная терапия включением в каждодневное меню больного пищи богатой элементами в виде железа и фолиевой кислоты.
Причины, ввиду которых индекс МСНС повышен
Повышение средней концентрации описываемого железосодержащего белка в элементах обусловлено:
- Нарушением водного баланса в организме человека;
- Гиперхромными анемиями;
- Нормальным явлением у младенцев.
Важно! Повышенный показатель Mchc до 380 гр./л и больше может кристаллизовать железосодержащий белок (хотя такое случается нечасто) и как следствие изменить, или полностью разрушить присутствующие в системе кроветворения тельца.
Но с большой долей вероятности повышенный индекс является именно ошибочной халатностью медиков допущенной в период лабораторных исследований:
- Неправильным определением железосодержащего белка и гематокрита;
- Неверным забором анализа, его хранением.
Иные причины повышенной концентрации белка обусловлены состояниями в виде:
- Овалоцитоза;
- Врожденного или приобретенного сфероцитоза.
Сфероцитоз является наследственной патологией, относящейся к анемиям гемолитического характера, проявляющейся дефективностью клеточных перегородок кровяных телец. То есть, когда описываемые клетки, жизнедеятельность которых обозначена 120 сутками, в силу каких-либо причин начинают разрушаться, так и не достигнув своей полной зрелости. А сниженная выработка описываемых клеток костным мозгом приводит в итоге к понижению имеющегося железосодержащего белка.
Необходимая терапия при повышенном индексе МНСН
Не нужно паниковать, если результаты лабораторных анализов указывают на имеющееся у пациента повышение Mchc. В первую очередь необходимо прислушаться к рекомендациям врача, который, скорее всего, назначит обильное питье и включит в каждодневный рацион продукты с высоким содержанием в них соли.
Также из своего привычного меню в обязательном порядке необходимо будет исключить плоды фруктов и ягод красного окраса, а также печень, ту или другую крупу и красные мясные ингредиенты. Кроме того, при подобном диагнозе нужно будет совершенно отказаться от употребления алкогольных напитков, жаренных и жирных компонентов той или иной еды.
Снизить МНСН помогут лекарственные препараты в виде: Курантила, Кардиомагнила, Трентала и других средств.
Также, если повышена концентрация железосодержащего белка в клетках, под запретом к употреблению должны находиться все витамины группы «В», а также фолиевая кислота.
Поэтому при общей слабости и быстрой утомляемости необходимо обратиться к врачу за рекомендациями и сдачей анализа для исключения возможной анемии, и ее последствий.